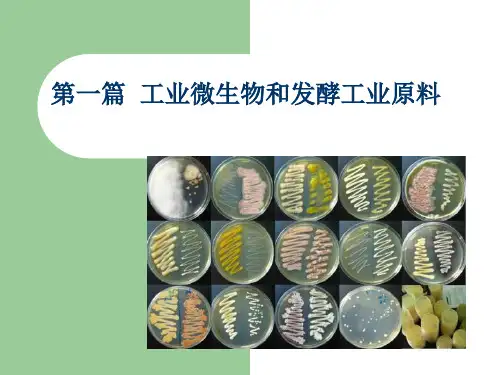

灭菌及无菌空气的制备
- 格式:ppt
- 大小:5.85 MB
- 文档页数:50





标准无菌空气制备流程各环节的作用英文回答:The standard aseptic air preparation process consists of several steps, each with its own purpose and role. Here, I will explain each step and provide examples to illustrate their importance.1. Filtration: This is the initial step where the air is passed through a high-efficiency particulate air (HEPA) filter to remove any particles or contaminants. The HEPA filter is designed to trap particles as small as 0.3 micrometers, ensuring that the air is clean and free from any potential sources of contamination. For example, in a pharmaceutical manufacturing facility, the air used in the cleanroom is filtered to remove dust, bacteria, and other contaminants that could compromise the quality of the products being produced.2. Sterilization: After filtration, the air issubjected to a sterilization process to eliminate any remaining microorganisms. This is typically achieved through the use of ultraviolet (UV) radiation or heat. UV radiation damages the DNA of microorganisms, rendering them unable to reproduce and causing their death. Heat sterilization, on the other hand, involves exposing the air to high temperatures to kill any microorganisms present. For instance, in a hospital operating room, the air is sterilized to reduce the risk of surgical site infections and ensure a sterile environment for the surgical team.3. Pressurization: Once the air has been filtered and sterilized, it is pressurized to create a positive pressure environment. This helps to prevent the entry of contaminants from outside the controlled area. For example, in a cleanroom used for semiconductor manufacturing, the positive pressure prevents outside air from entering and contaminating the sensitive electronic components being produced.4. Monitoring: Throughout the process, the quality of the aseptic air is continuously monitored to ensure that itmeets the required standards. This is done by regularly sampling the air and testing it for the presence of microorganisms or other contaminants. If any deviations from the acceptable limits are detected, corrective actions can be taken to maintain the integrity of the aseptic environment. For instance, in a biotechnology laboratory, air samples may be collected and analyzed to ensure that the environment is free from any microbial contamination that could affect the experiments being conducted.In summary, the various steps in the standard aseptic air preparation process work together to ensure that theair used in controlled environments is clean, sterile, and free from any potential sources of contamination.Filtration removes particles and contaminants,sterilization eliminates microorganisms, pressurization prevents the entry of outside contaminants, and monitoring ensures the ongoing quality of the aseptic air.中文回答:标准无菌空气制备流程包括几个环节,每个环节都有其特定的作用和角色。


简述无菌空气的制备流程下载温馨提示:该文档是我店铺精心编制而成,希望大家下载以后,能够帮助大家解决实际的问题。
文档下载后可定制随意修改,请根据实际需要进行相应的调整和使用,谢谢!并且,本店铺为大家提供各种各样类型的实用资料,如教育随笔、日记赏析、句子摘抄、古诗大全、经典美文、话题作文、工作总结、词语解析、文案摘录、其他资料等等,如想了解不同资料格式和写法,敬请关注!Download tips: This document is carefully compiled by theeditor. I hope that after you download them,they can help yousolve practical problems. The document can be customized andmodified after downloading,please adjust and use it according toactual needs, thank you!In addition, our shop provides you with various types ofpractical materials,such as educational essays, diaryappreciation,sentence excerpts,ancient poems,classic articles,topic composition,work summary,word parsing,copy excerpts,other materials and so on,want to know different data formats andwriting methods,please pay attention!1. 空气预处理。
目的,去除空气中的灰尘、杂质和微生物,为后续的过滤和灭菌提供清洁的空气。